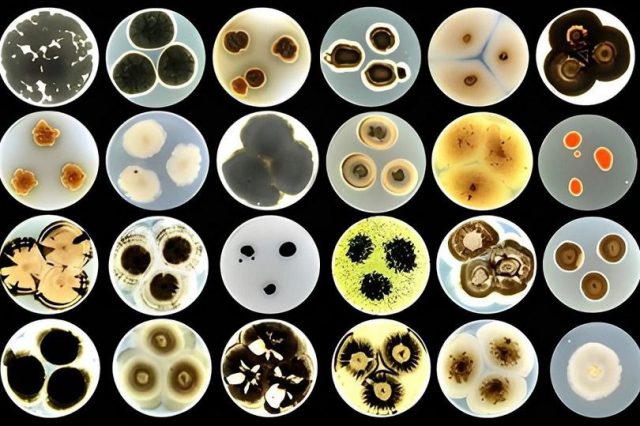
68

Оңтүстік Корея ғалымдары табиғи материалдарды пайдаланып, адам миының жұмысын толықтай қайталайтын жасанды синапс жасап шығарды. Бұл құрылғы энергияны аз жұмсайды және пайдаланғаннан кейін топырақта толық ыдырап кетеді. Мамандардың айтуынша, өнертабыс болашақта экологиялық таза нейроморфтық чиптер мен жаңа буын жасанды интеллект құрылғыларының негізін қалауы мүмкін.
Қазіргі заманғы электрондық компоненттер, соның ішінде жасанды интеллект жүйелеріндегі синапстар, көп энергия талап етеді және электрондық қалдықтар мәселесін ушықтырады. Көптеген құрылғыларды қайта өңдеу қиын материалдардан жасалады.
Ульсан ұлттық ғылым және технология институтының зерттеушілері тек табиғи материалдардан тұратын биоыдырайтын жасанды синапс ойлап тапты. Ол адамның миына тән оқу және есте сақтау механизмдерін толық қайталауға қабілетті.
Микроскопиялық чиптің көпқабатты құрылымы бұршақ, ракообразный қабықтары және өсімдік талшықтарына негізделген целлюлоза ацетатынан жасалған ядродан тұрады. Қосымша құрамда хитин және басқа да табиғи полимерлер бар.
Құрылғыға электр импульсі берілген кезде натрий иондары бөлініп шығып, мидағы нейромедиаторлардың қызметін қайталайды. Иондар құрылым ішінде бекітіліп, энергия болмаса да ақпаратты сақтауға мүмкіндік береді, қысқа және ұзақ мерзімді есте сақтау функцияларын қалыптастырады.
Зерттеулер көрсеткендей, жасанды синапс ақпаратты шамамен 100 минутқа дейін сақтай алады – бұл биоыдырайтын баламалар арасындағы ең ұзақ көрсеткіш. Ал энергия тұтынысы адам миымен салыстырғанда әлдеқайда төмен: әр сигналға тек 0,85 фемтоджоуль жұмсалады, ал адам миы бір оқиға үшін 2,4–24 фемтоджоуль тұтынады.
Технологияның әлеуетін көрсету үшін синапс қарапайым роботтық жүйеге енгізілді. Жылуды сезгенде құрылғыдағы иондардың қозғалысы сигналды күшейтіп, роботтың қолын бірден кері шегіндіреді. Бұл адам миындағы негізгі рефлекске ұқсас әрекет болып табылады.
Жұмыс аяқталған соң, чиптің барлық қабаттары 16 күн ішінде топырақта толық ыдырап, зиянды қалдық қалдырмайды. Мұндай технология қоршаған ортамен қауіпсіз әрекеттесетін, үйренетін және бейімделетін жасанды интеллект құрылғыларын жасауға жол ашады.